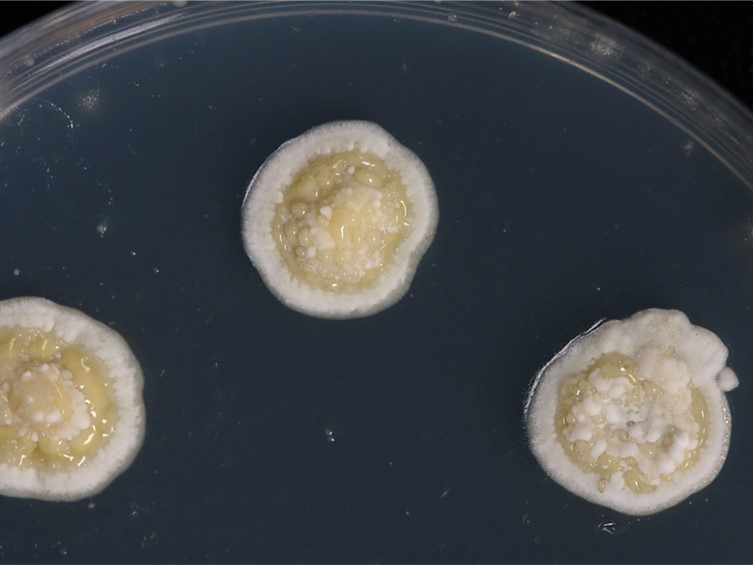

Holotype:
THAILAND, Narathiwat Province, Hala Bala Wildlife Sanctuaryk, 23 Aug. 2011, A. Khonsanit, holotype BBH 31089, ex-type living culture BCC 49409.
Habitat:
Underside of dicotyledonous leaves.
Host:
Whitefly nymphs (Hemiptera).
Description:
 Sexual morph: stroma flattened pulvinate, white, 3-6 × 1-1.5 mm; tubercles arising from a thin pulvinate base, separated from one another and located at the margin of the stroma when conidiomata are present in the center. Tubercles cylindrical, 500-600 μm in height, 350-480 μm diam.
Sexual morph: stroma flattened pulvinate, white, 3-6 × 1-1.5 mm; tubercles arising from a thin pulvinate base, separated from one another and located at the margin of the stroma when conidiomata are present in the center. Tubercles cylindrical, 500-600 μm in height, 350-480 μm diam.  Perithecia develop singly in a tubercle, flask-shaped, 300-550 μm in height, 250-300 μm diam.
Perithecia develop singly in a tubercle, flask-shaped, 300-550 μm in height, 250-300 μm diam.  Asci cylindrical, 152-280 × 610 μm, with a cap approx. 4 μm thick.
Asci cylindrical, 152-280 × 610 μm, with a cap approx. 4 μm thick.  Ascospores disarticulating into part-spores inside the ascus which are narrowly cylindrical, slightly tapering towards the ends, 11-16 × 1.5-2.5 μm.
Ascospores disarticulating into part-spores inside the ascus which are narrowly cylindrical, slightly tapering towards the ends, 11-16 × 1.5-2.5 μm.  Asexual morph: stroma white in fresh specimens, flattened pulvinate, very thin, surrounded by a hyaline hypothallus, 0.2-0.5 μm thick, 1-4 μm diam.
Asexual morph: stroma white in fresh specimens, flattened pulvinate, very thin, surrounded by a hyaline hypothallus, 0.2-0.5 μm thick, 1-4 μm diam.  Conidioma appearing as shallow depressions in the center of the stroma, forming a ring, 140-200 × 150-180 μm, globose, with yellowish white conidial masses.
Conidioma appearing as shallow depressions in the center of the stroma, forming a ring, 140-200 × 150-180 μm, globose, with yellowish white conidial masses.  Conidiogenous cells cylindrical, up to 22 μm long, 1-2 μm wide.
Conidiogenous cells cylindrical, up to 22 μm long, 1-2 μm wide.  Conidia fusoid, tapering slightly toward the ends, 8-12 × 1.5-3 μm. No paraphyses observed.
Conidia fusoid, tapering slightly toward the ends, 8-12 × 1.5-3 μm. No paraphyses observed.
Culture characteristics:
Colonies on PDA approx. 1 cm diam after 4 wk. The stromatic colonies were white, forming compact stromata. The cream-colored conidial masses produced a scattered covering over the surface of the stromatic colonies after 4 wk.
Colonies on PDA approx. 1 cm diam after 4 wk. The stromatic colonies were white, forming compact stromata. The cream-colored conidial masses produced a scattered covering over the surface of the stromatic colonies after 4 wk.
Reference:
Mongkolsamrit S, Khonsanit A, Noisripoom W, et al. (2015). Two new entomogenous species of Moelleriella with perithecia in tubercles from Thailand. Mycoscience 56: 66–74.
DOI: https://doi.org/10.1016/j.myc.2014.03.002Species |
Strain |
Compound |
Pubchem CID |
Biological activity |
Reference |
|---|
|
Strain |
LSU | RPB1 |
|---|---|---|
| BCC 49409 | JQ269646 | JQ256906 |
| BCC 49492 | JQ269645 | JQ256905 |